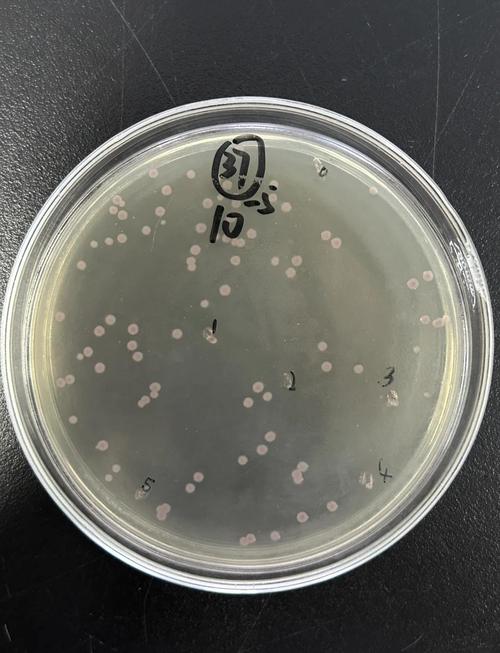
新生儿人亚种葡萄球菌-第1张图片-郑州医学网

什么是人葡萄球菌?
- 分类:人葡萄球菌属于葡萄球菌属,是一种革兰氏阳性球菌,因为它在显微镜下排列像一串葡萄,所以得名“葡萄球菌”。
- 特点:与更常见的金黄色葡萄球菌相比,人葡萄球菌的毒力较弱,致病性也相对较低,它是人类皮肤和上呼吸道(如鼻腔)的正常菌群之一,属于条件致病菌。
- 名称来源:“人”这个种名表明它主要与人类相关,是定植在人体上的特有菌种之一。
新生儿与人葡萄球菌的关系
新生儿是人葡萄球菌的主要宿主之一,这种细菌的传播和定植过程非常普遍:
- 来源:新生儿主要从母亲、医护人员和家庭环境中获得人葡萄球菌,分娩过程中,新生儿会经过产道,接触到母亲皮肤和阴道中的菌群,之后,家人和医护人员在护理(如拥抱、抚摸、换尿布)时,也会将细菌传递给新生儿。
- 定植部位:新生儿最常见的定植部位是鼻前庭(鼻腔深处)、脐部、皮肤褶皱处(如腋下、腹股沟)和会阴部。
- 普遍性:在新生儿重症监护室中,人葡萄球菌的定植率非常高,这是非常正常的现象。定植本身不代表生病,只是意味着细菌在这些部位安了家。
人葡萄球菌在新生儿中可能引起的感染
虽然人葡萄球菌毒力不强,但新生儿的免疫系统尚未发育成熟,皮肤黏膜屏障功能脆弱,因此当某些“诱因”出现时,它就可能突破防线,引起感染。
常见的感染类型包括:
-
皮肤和软组织感染:
- 脓疱疮:表现为皮肤上出现薄壁的水疱,很快变为脓疱,破裂后露出红色湿润的糜烂面,是新生儿常见的皮肤感染。
- 小脓肿:在皮肤下形成充满脓液的小包块。
- 脐炎:脐部护理不当,细菌侵入导致脐部红肿、有分泌物,甚至有臭味。
-
菌血症/败血症:
(图片来源网络,侵删)- 这是最严重的感染之一,当细菌进入血液并扩散到全身时,可引起败血症。
- 症状:新生儿可能表现为不吃奶、精神萎靡、体温不稳定(发热或体温不升)、呼吸急促、心率快、肤色苍白或发灰等,这是一个需要立即就医的紧急情况。
-
其他感染:
在极少数情况下,也可能引起眼部感染(如结膜炎)、尿路感染等。
新生儿感染的危险因素
为什么有些新生儿会感染,而有些不会?这通常与以下危险因素有关:
- 早产儿/低出生体重儿:免疫系统极不成熟,是感染的最高危人群。
- 皮肤黏膜屏障受损:如存在皮肤擦伤、湿疹、脐部残端未脱落等。
- 医疗侵入性操作:如使用静脉置管(PICC、CVC)、气管插管、导尿管等,为细菌进入体内提供了“通道”。
- 长期住院:尤其是在NICU,更容易接触到多种细菌。
- 母亲有感染:如母亲在分娩前有发热或感染史。
如何预防和护理?
对于新生儿,尤其是高危儿,预防人葡萄球菌感染至关重要:

-
手卫生是第一要务:
- 接触宝宝前,无论是父母还是医护人员,都必须用肥皂和流动水彻底洗手,或使用含酒精的免洗洗手液。
- 这是切断传播途径最有效的方法。
-
做好脐部护理:
保持脐部干燥、清洁,出院时医生通常会指导如何护理,一般用75%的酒精消毒脐根部的残端,直到它自然脱落并完全愈合。
-
保持皮肤清洁:
- 每天给宝宝洗澡,保持皮肤干爽,特别是注意清洁皮肤褶皱处。
- 及时更换尿布,防止尿布疹,避免皮肤破损。
-
避免不必要的接触和探访:
在新生儿期,尤其是前几个月,尽量减少亲友的探访,避免让过多的人亲吻、触摸宝宝,如果有人感冒或患有皮肤感染,应绝对避免接触宝宝。
-
医疗环境的防护:
在NICU等环境中,医护人员会严格执行隔离措施,以防止交叉感染。
治疗方法
如果新生儿不幸感染了人葡萄球菌,医生会根据感染部位和严重程度采取相应的治疗措施:
- 局部感染:如小的脓肿,可能只需切开引流,皮肤感染可外用抗生素药膏。
- 全身性感染:如败血症,则需要立即静脉使用抗生素进行治疗,医生会根据药敏试验结果选择最敏感的抗生素,以确保治疗效果。
人葡萄球菌是新生儿皮肤和黏膜上的常客,绝大多数情况下是无害的。 父母不必对此感到过度恐慌,关键在于预防——通过严格的手卫生和精心的日常护理,为宝宝建立一道坚固的防线,要密切关注宝宝的状态,一旦出现精神差、吃奶少、体温异常等警示信号,应立即就医,让专业医生进行诊断和治疗。
标签: 新生儿葡萄球菌感染症状 新生儿人葡萄球菌治疗 新生儿葡萄球菌预防措施